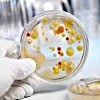

Другие названия и синонимы
Sowing for mycoplasma with the determination of sensitivity in women.
Описание
Посев на наличие микоплазмоза вместе с определением чувствительности является бактериологическим методом выращивания возбудителя (Mycoplasma hominis) на средах. В бактерицидных условиях определяют отсутствие или присутствие роста микоплазмы, проводят количественную оценку патогенных микроорганизмов и чувствительность к антибиотикам. Показаниями к инокуляции при наличии микоплазмоза являются воспалительные изменения мочеполового тракта, поиск причины бесплодия, объяснение данных ИФА и диагностика ПЦР. По результатам посадки на наличие микоплазм врач принимает решение о целесообразности и характере конкретного лечения.
Посев на наличие микоплазмоза вместе с определением чувствительности является бактериологическим методом выращивания возбудителя (Mycoplasma hominis) на средах. В бактерицидных условиях определяют отсутствие или присутствие роста микоплазмы, проводят количественную оценку патогенных микроорганизмов и чувствительность к антибиотикам. По результатам посадки на наличие микоплазм врач принимает решение о целесообразности и характере конкретного лечения.
Микоплазма (Mycoplasma hominis) относится к группе урогенитальных микоплазм. Микоплазмы являются условно-патогенными микроорганизмами и часто встречаются у здоровых людей. Его патогенность зависит от определенных условий, концентрации, наличия в организме другой патогенной флоры (трикомонады, хламидии, гонококки и ).
Преимущественное заражение микоплазмой происходит половым путем, также возможна вертикальная инфекция плода во время беременности или инфекция во время родов. Микоплазмы - это внутриклеточные паразиты, которые населяют клеточные мембраны хозяина, вызывая нарушение клеточных функций и местные воспалительные реакции. Микоплазмоз характеризуется латентным течением с обострениями, хроническим течением или рецидивом процесса под влиянием нескольких факторов.
У женщин микоплазмы колонизируют влагалище, шейку матки, реже мочеиспускательный канал и вызывают цервицит, уретрит и воспалительные процессы в органах малого таза (оофорит, сальпингит, аднексит, эндометрит и ). Риск микоплазмоза представляет собой нарушение репродуктивной функции (бесплодие), риск прерывания и преждевременных родов, внутриутробную инфекцию плода. Поскольку клинические проявления микоплазмоза довольно полиморфны, а иногда и загадочны для диагностики особой роли, которую их лабораторный диагноз играет с помощью ПЦР, ИФА и бактериологического посева на селективной питательной среде.
Использование вacposev против микоплазмоза рекомендуется, если есть признаки воспаления мочеполовой системы с бесплодием, чтобы уточнить результат после диагностики ПЦР и ИФА и контролировать эффективность лечения микоплазмоза.
Диагностический материал берется до начала антибиотикотерапии, в любой день цикла, кроме дней менструального кровотечения. Также за день до исследования рекомендуется исключить половой контакт, применение вагинальных свечей, спринцевание.
Материалом для бактериологического посева на микоплазмоз с определением чувствительности является выскабливание эпителиальных клеток из дуг влагалища, из цервикального канала, уретры. Место соскоба обрабатывают стерильным физиологическим раствором. Мазок забирают стерильным тампоном (зондом), используя вращательные движения, захватывая эпителиальные клетки. Затем конец зонда помещают в стерильную пробирку. Перед доставкой в лабораторию собранный материал следует хранить в термостате при 37 ° с или при комнатной температуре.
Семя производится в специальной среде для определения микоплазмы. При оценке результата важны количественные показатели: при определении титра выше 104 КОЕ / мл микоплазма может рассматриваться как этиологический фактор патологического процесса. Микоплазмоз Бакпозева позволяет определить чувствительность возбудителя к антибактериальным средствам, что крайне важно для последующего лечения.
К недостаткам метода диагностики микоплазмоза относятся длительность исследования (около 1 недели) и зависимость достоверности результата от наличия живых микоплазм при соскобе.
Посев на наличие микоплазмоза вместе с определением чувствительности является бактериологическим методом выращивания возбудителя (Mycoplasma hominis) на средах. В бактерицидных условиях определяют отсутствие или присутствие роста микоплазмы, проводят количественную оценку патогенных микроорганизмов и чувствительность к антибиотикам. По результатам посадки на наличие микоплазм врач принимает решение о целесообразности и характере конкретного лечения.
Микоплазма (Mycoplasma hominis) относится к группе урогенитальных микоплазм. Микоплазмы являются условно-патогенными микроорганизмами и часто встречаются у здоровых людей. Его патогенность зависит от определенных условий, концентрации, наличия в организме другой патогенной флоры (трикомонады, хламидии, гонококки и ).
Преимущественное заражение микоплазмой происходит половым путем, также возможна вертикальная инфекция плода во время беременности или инфекция во время родов. Микоплазмы - это внутриклеточные паразиты, которые населяют клеточные мембраны хозяина, вызывая нарушение клеточных функций и местные воспалительные реакции. Микоплазмоз характеризуется латентным течением с обострениями, хроническим течением или рецидивом процесса под влиянием нескольких факторов.
У женщин микоплазмы колонизируют влагалище, шейку матки, реже мочеиспускательный канал и вызывают цервицит, уретрит и воспалительные процессы в органах малого таза (оофорит, сальпингит, аднексит, эндометрит и ). Риск микоплазмоза представляет собой нарушение репродуктивной функции (бесплодие), риск прерывания и преждевременных родов, внутриутробную инфекцию плода. Поскольку клинические проявления микоплазмоза довольно полиморфны, а иногда и загадочны для диагностики особой роли, которую их лабораторный диагноз играет с помощью ПЦР, ИФА и бактериологического посева на селективной питательной среде.
Использование вacposev против микоплазмоза рекомендуется, если есть признаки воспаления мочеполовой системы с бесплодием, чтобы уточнить результат после диагностики ПЦР и ИФА и контролировать эффективность лечения микоплазмоза.
Диагностический материал берется до начала антибиотикотерапии, в любой день цикла, кроме дней менструального кровотечения. Также за день до исследования рекомендуется исключить половой контакт, применение вагинальных свечей, спринцевание.
Материалом для бактериологического посева на микоплазмоз с определением чувствительности является выскабливание эпителиальных клеток из дуг влагалища, из цервикального канала, уретры. Место соскоба обрабатывают стерильным физиологическим раствором. Мазок забирают стерильным тампоном (зондом), используя вращательные движения, захватывая эпителиальные клетки. Затем конец зонда помещают в стерильную пробирку. Перед доставкой в лабораторию собранный материал следует хранить в термостате при 37 ° с или при комнатной температуре.
Семя производится в специальной среде для определения микоплазмы. При оценке результата важны количественные показатели: при определении титра выше 104 КОЕ / мл микоплазма может рассматриваться как этиологический фактор патологического процесса. Микоплазмоз Бакпозева позволяет определить чувствительность возбудителя к антибактериальным средствам, что крайне важно для последующего лечения.
К недостаткам метода диагностики микоплазмоза относятся длительность исследования (около 1 недели) и зависимость достоверности результата от наличия живых микоплазм при соскобе.

|